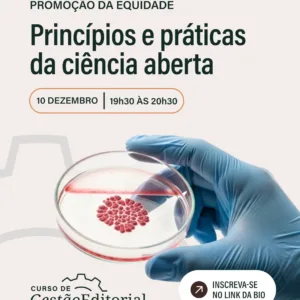

dezembro 2025
02 dezembro 2025
04 dezembro 2025
09 dezembro 2025
10 dezembro 2025
ABN LAB | Curso de Gestão Editorial
19:30 - 20:30
março 2026
05 março 2026
07 março 2026
07 março 2026
Congresso de Neurociências do Piauí (CONPI)
08:00 - 00:00
20 março 2026
21 março 2026
21 março 2026
ABN Summit Sul
All Day
abril 2026
09 abril 2026
11 abril 2026
11 abril 2026
17 abril 2026
18 abril 2026
18 abril 2026
ABN Summit Norte
All Day
maio 2026
07 maio 2026
08 maio 2026
08 maio 2026
15 maio 2026
16 maio 2026
16 maio 2026
ABN Summit Sudeste
All Day
22 maio 2026
23 maio 2026
23 maio 2026
ABN Summit Centro-Oeste
All Day
29 maio 2026
30 maio 2026
30 maio 2026
ABN Summit Nordeste
All Day
junho 2026
27 junho 2026
30 junho 2026
30 junho 2026
12th Congress of the European Academy of Neurology (EAN) 2026
12th Congress of the European Academy of Neurology (EAN) 2026 – Geneva, Switzerland from 27–30 June 2026 Join us for the 12th EAN Congress in the vibrant city of Geneva! Under the overarching theme “Brains, Bytes & Beyond: Tech in Neurology”, the congress will explore how technological innovation and artificial intelligence are transforming the field… ...
All Day
outubro 2026
07 outubro 2026
10 outubro 2026
10 outubro 2026
Nenhum evento encontrado!